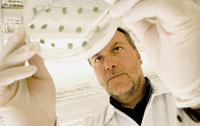
man with petri dish

Within the European Commission (EC), there is increasing recognition that biotech SMEs are important drivers of innovation. In July 2010, the EC committed €6.4bn to research and innovation in the sector. Some national governments have also taken a hand in funding innovation. In France, for example, OSEO – a collaboration between the innovation agency ANVAR and the development bank BDPME – is financing biotech companies.
Nevertheless, biotech SMEs face a difficult journey towards financial sustainability and success. During 2010, they operated against a backdrop of slow economic recovery, cost-cutting governments and a reorganising pharmaceutical sector. Public markets were almost closed, and venture capitalists (VCs) were reluctant to invest, particularly in early-stage companies. Times were tough in Europe in 2010, reports Tom Saylor, chair of EuropaBio’s SME Platform and ceo of Arecor, but are getting better. Nathalie Moll, secretary-general of EuropaBio, the European association for bioindustries, continues this positive note. The availability of venture capital (VC) and opportunities for deals with Big Pharma has certainly improved, she says. However, she adds, deals now seem to require a ‘market-aimed’ approach where funding is no longer for blue-sky research but is linked to a clear target, specified either by the VCs or by the pharma company, or a combination of the two.
The San Francisco-based merchant bank Burrill & Company reported on the global biotech sector in March,1 concluding that public European companies had faced a difficult financing environment in 2010. Most of the success stories were French, it reports, as the biotech sector there received ‘heavyweight support’ from a fiscal stimulus package established in 2008. Of the eight European initial public offerings or IPOs completed in the sector, seven were French-based. Privately held companies in France, Germany and the UK ‘enjoyed a fairly robust’ VC climate, the report continues. But mainly ‘the appetite for biotech investment was tepid.’ Several clinical trial failures provided would-be investors with more reasons to steer clear of the high-risk sector. But ‘one glimmer of hope’ was the $20m investment in September 2010 by the US Biotechnology Value Fund in the Swiss biotech Addex Pharmaceutical, ‘suggesting that valuations are getting to a level where investors are finally ready to play.’
Funding opportunities
While VC is perhaps the most important capital source for European biotech companies, the industry has been particularly hit by the economic downturn. Partly because VC firms are having difficulty in raising capital themselves, they are playing a less significant role than in the past, says Saylor. In the past decade, even the top VC firms have not seen a return on investments. The result is even less money for cash-hungry biotechs.
There has also been a change in approach adopted by the VCs, Moll explains. ‘VCs in Europe are looking for companies that will engage in market-oriented discussions early on. It’s difficult to judge at such an early stage whether this is a cause for concern but it is certainly a change of operating procedures,’ she says.
One of the problems facing biotechs is that VCs need to see a return on their investment and five to six years is sometimes a short period if you take into account the long development times for pharmaceutical products, says Johanna Holldack, ceo of Swiss company Telormedix. In 2008, Telormedix raised CHF21m in VC funding, in one of the biggest financing rounds in Europe that year. ‘We are still living on that money,’ says Holldack. ‘We have been very lucky that our investors understand our business and accept that timelines may have to be prolonged. The key for success for any given company is that management and investors agree and understand each other.’
Private investors also have a role to play. ‘Private investors have always been crucial,’ says Moll. ‘Banks and public institutional funding tend to have a number of caveats, are difficult to access, or are not well adapted to the needs of biotech SMEs. Private investors from the “business angel” stage to the later stage will continue to play a key role.’
Saylor agrees that private investors are important at a company’s early stage, but problems can emerge later. ‘If they do not get a return on their investments over a limited time, they will stop supplying capital,’ he explains.
Private financing has given German company Scil Proteins funding to bring pre-clinical candidate compounds into the clinic by 2013, says Henning Afflerbach, the company’s chief business officer. Coral BioNet made a long-term commitment to Scil Proteins at its start-up in 1999, and agreed to provide a further €24m in 2010. Afflerbach comments: ‘As private investors they are not so much exit-driven as VCs, but work closely in contact with us and share our ideas, long-term planning and perspective.’
European research programmes can be an excellent way of getting early financing. The EU’s Research Framework Programmes (FP) have invested substantially in European biotech research. The FP7 project, for example, has allocated €6bn to cooperative health research for the period 2007–13. Out of this about 14% is expected to go to biotech-related health projects. In a FP7 project, SMEs can get up to 75% of the eligible costs for research activities and 50% for demonstration activities. ‘Given the risk and capital-intensive nature of biotech, more effective use of existing funding programmes, such as FP7, can be crucial to providing capital to bridge the shortfall from other sources,’ Saylor remarks.
Grassauer believes that access to research funding is one of the key success factors for a SME, since it allows a company to develop riskier projects with high potential. ‘In Austria, we have a stable commitment from the government for investment into R&D. In particular, Vienna is an excellent place for biotech research. Besides an excellent academic environment, funding is provided on a national and local level flanked by tax benefits.’ Others are more cautious in the value of research funding. Holldack points out that there are sometimes complications. ‘For some European research programmes, more than one company has to be involved, which can be challenging when it comes to agreeing issues such as intellectual property rights,’ she says.
Public markets
Public markets, which are particularly important for companies in the later stages of developing new drugs, have been all but closed to biotech over the past decade, says Saylor. ‘At one time, public markets were an important access for investors. Now, the only practical way to realise investment is to sell to Big Pharma, and then you can’t always pick your timing.’

‘Compared with the US,’ he concludes, ‘Europe has a key disadvantage: it has a big gap in intermediate, later-stage funding. In the US, public markets are a source of later-stage finance.’
The problem is that European biotechs are having trouble getting to the development and clinical trials phase that would make them interesting for public markets, suggests Moll. ‘They struggle to get the funds to bridge the “valley of death”, the period when a company has done the research, found a product to develop but needs major investments to carry out Phase I and II clinical trials for proof of concept,’ she says.
Meanwhile, Steven Burrill, ceo of Burrill & Company, urges the Europeans to be more upbeat. ‘It’s true that public markets are not as attractive as in the US, but a good company with a good technology, good management and a market opportunity will always find funding.’
More generally, Burrill takes Europeans to task for complaining about lack of funding: ‘It is easy for Europeans to say there is no capital available. There is capital, but it is more expensive than it used to be. For example, an investor providing $10m may once have been content with 10% of a company; now he wants 50%.’
Burrill’s big message is ‘think global’. ‘There are many more markets out there than just North America and Europe’, he says. ‘The rest of the world used to be insignificant, but now Asia and Latin America are booming. Opportunities for capital and markets have never been bigger if companies think globally.’
Big Pharma restructures
As Big Pharma restructures, there could be opportunities for biotech SMEs. With escalating R&D expenditures, fewer new drug approvals, increasing regulatory demands, and the loss of revenue to generics as patents expire on their blockbuster drugs, the pharmaceutical industry is turning to biotechnology, says Burrill. ‘Big Pharma are in trouble. These companies have seen the loss of $1tn in value during the past decade. They can no longer provide cheap capital to biotech. However, this is a big opportunity. Rather than “research and develop”, Big Pharma is looking to “search and develop”. They are outsourcing their innovation and they are no longer as aggressive.’
Pharmaceutical companies today, he says, are pursuing acquisitions of innovative biotech products and companies. ‘But they are now taking steps to leave in place the culture of these companies to protect the innovation they covet. In other instances, Big Pharma is seeking to emulate biotechs through new R&D models that create small, focused, independent research units that operate much like biotechs.’
Emerging SMEs now represent as much as 30– 50% of the pipeline for many major companies, according to a report by EuropaBio in January 2011.2 ‘There is a growing recognition of a symbiotic relationship,’ says Saylor. ‘SMEs play an intermediary role of great benefit: they provide Big Pharma with a bridge to the science base. Big Pharma is increasingly seeing that SMEs can partially “de-risk” the development process.’
As Big Pharma changes, so does its requirements, Holldack has found. ‘In general, Big Pharma is looking for earlier stage companies than in the past. A couple of years ago I wouldn’t have dared to talk to a Big Pharma about an early-stage compound. Now some companies are actively looking to fill their early-stage pipelines. This is good news for biotechs. To a certain degree, Big Pharma can chip in where there is a lack of VC.’
On the other hand, Holldack notes that upfront payments in deals made in the past 18 months seem low. ‘It’s possible that Big Pharma is benefiting from a lack of funding for biotechs, and getting cheaper deals’, she says.
Outlook
For biotech SMEs to flourish in Europe, the sector needs to attract more venture capital and get better access to finance, such as European Investment Bank loans, says Saylor. Applying for EC funding also needs to get simpler, faster and less resource-intensive.
But overall, Saylor is cautiously optimistic going forward. His big concern is later-stage funding: ‘We have an extremely strong science base in Europe and a growing number of experienced entrepreneurs, investors and angels willing to seed their investment, but we lack a pathway to value at the later stage of investment. We have to be creative at finding ways to get money.’
Steven Burrill is also bracingly upbeat: ‘Companies looking for investment may need to dig around to make it happen, but it is possible. There is capital out there; you just have to try harder to make it happen.’ He continues: ‘Think globally, not parochially, for markets, science and capital. There are huge market needs and pulls, and biotech can answer them. It has a 40 year history; it has the right technology at the right time. This industry has never had a greater presence or opportunity.’
References
1. Biotech 2011-Life Sciences: Looking Back to See Ahead, http://www.burrillandco.com/resources.html.
2. Sustainable Biotech SMEs: drivers for innovation, http://www.europabio.org/positions/general/SME_bro_ light.pdf.

